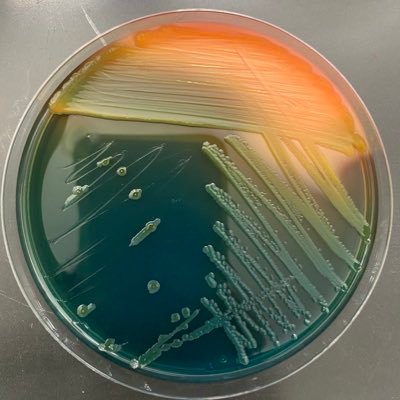
KileyLewin's profile picture. A true nerd at heart I love reading, bacteria, constantly learning and sharing fun facts with others.

#questionablemethods 検索結果
Whelp, I hopped around three to four different WIPs today and I don't think I actually accomplished anything. #WritingCommunity #amwriting #questionablemethods
Awesome. Clear the deficit, come out of bankruptcy, and try to convince investors to come to Ontario. Tall order. #QuestionableMethods
Good Morning! When you make do with what you’ve got because you still cannot find anything #improvise #questionablemethods #microbiology
Made it into the car..? #questionablemethods? http://lockerz.com/s/108111213
lockerz.com
9+ Sanrio Clothing Themes For Adults (Kawaii Outfit Aesthetic & More Tips) - Lockerz
Hello Kitty, My Melody, and Keroppi might seem like a strange assortment of characters to some, but for the people ... Read more
Time for some vocal warmups #secrettechnique #vocalwarmups #questionablemethods #vocals #singing… instagram.com/p/9l5X6LydYt/
new low point - having a dream about what will come up in my exam and now just only learning that. #questionablemethods
@jomo_8 keep telling me that but I keep recalling me beating you! #hmmmm #questionablemethods
I'm always up for a challenge, especially when it comes to work. The crazier, the better. Bring on the impossible, I'm ready to twist it into reality. #ChallengeAccepted #TwistedMindset #QuestionableMethods 💪😈 just DM!!!
Toys R Us is two stores down from the headshop? #questionablemethods?
Argh my stats show that my honours project didn't work; only 1 significant correlation. Time to increase sample size! #questionablemethods
This documentary went from being about mothman to a dude having sex with a lipless woman alien who abducted him. #questionablemethods
@glenna_opt I... uhhhh... well... #hmmmm #questionablemethods #dontknockittillyoutryit
Why do we have the FOS? #Redstone #Nocustomercare #questionablemethods #beware #btl
Toree called. I can't wait to sell a kidney to visit her this summer. #questionablemethods
I totally didn't just food dye my fingertips purple. That'd be crazy. #questionablemethods
Kayla just demonstrated scooping on Yoda for @wokeupmad. #questionablemethods
My father texted to say that I should be proud cause he's at a Hinder concert. #questionablemethods?
Everytime The Hills Have Thighs is on, I think of @Minjock77. #questionablemethods
I'm always up for a challenge, especially when it comes to work. The crazier, the better. Bring on the impossible, I'm ready to twist it into reality. #ChallengeAccepted #TwistedMindset #QuestionableMethods 💪😈 just DM!!!
Good Morning! When you make do with what you’ve got because you still cannot find anything #improvise #questionablemethods #microbiology
Whelp, I hopped around three to four different WIPs today and I don't think I actually accomplished anything. #WritingCommunity #amwriting #questionablemethods
Awesome. Clear the deficit, come out of bankruptcy, and try to convince investors to come to Ontario. Tall order. #QuestionableMethods
Also, the texting the people in Ottawa thing... really? People are okay with this? #Ottawa #investigatingmurderbytext #questionablemethods
Masterclass in making the bed #questionablemethods @ E9 Hackney instagram.com/p/BC6G0VAiZAS/
@carlykaiser @LDMcPherson How do you even find such places? #QuestionableMethods
Time for some vocal warmups #secrettechnique #vocalwarmups #questionablemethods #vocals #singing… instagram.com/p/9l5X6LydYt/
Why do we have the FOS? #Redstone #Nocustomercare #questionablemethods #beware #btl
@mattsorum I loved it, asked the question how far do you push someone who wants be great to achieve their potential #questionablemethods
Practicing bandages for tomorrow by tying a sock around my hand #Questionablemethods
Had me thinking my work was worth nothing then up pops an A #englishcoursework #questionablemethods
#questionablemethods “@electionista: #Hungary election “exit polls” were carried out by phone”
new low point - having a dream about what will come up in my exam and now just only learning that. #questionablemethods
Been sat watching the TV for 20 minutes...I should probably think about switching it on now!!! #thatsortofday #questionablemethods
@glenna_opt I... uhhhh... well... #hmmmm #questionablemethods #dontknockittillyoutryit
i am just acquiring lotsa movies presently with hopes that they will """"inspire me"""" for my film project #questionablemethods
@COYLE_UK wikipedia is not the answer....spark notes is. #questionablemethods
@AndrewKen95 @clachs does this mean I have to frost my tips too? Starting to second guess faruq… #questionablemethods
Whelp, I hopped around three to four different WIPs today and I don't think I actually accomplished anything. #WritingCommunity #amwriting #questionablemethods
Made it into the car..? #questionablemethods? http://lockerz.com/s/108111213
lockerz.com
9+ Sanrio Clothing Themes For Adults (Kawaii Outfit Aesthetic & More Tips) - Lockerz
Hello Kitty, My Melody, and Keroppi might seem like a strange assortment of characters to some, but for the people ... Read more
Something went wrong.
Something went wrong.
United States Trends
- 1. Kanata 17.6K posts
- 2. The BIGGЕST JUP AlRDROP 23.6K posts
- 3. #GMMTVxTPDA2025 48.1K posts
- 4. #JUPITER 93.3K posts
- 5. #ALLOCATION 93.1K posts
- 6. Lakers 49.5K posts
- 7. Dillon Brooks 7,434 posts
- 8. Hololive 14.3K posts
- 9. Bron 25.4K posts
- 10. Giants 86.6K posts
- 11. Patriots 134K posts
- 12. Dart 36.9K posts
- 13. #WWERaw 73.2K posts
- 14. #AvatarFireAndAsh 3,292 posts
- 15. Collin Gillespie 2,122 posts
- 16. Suns 19.7K posts
- 17. STEAK 10.5K posts
- 18. Drake Maye 24.8K posts
- 19. James Cameron 4,983 posts
- 20. Pats 16.2K posts